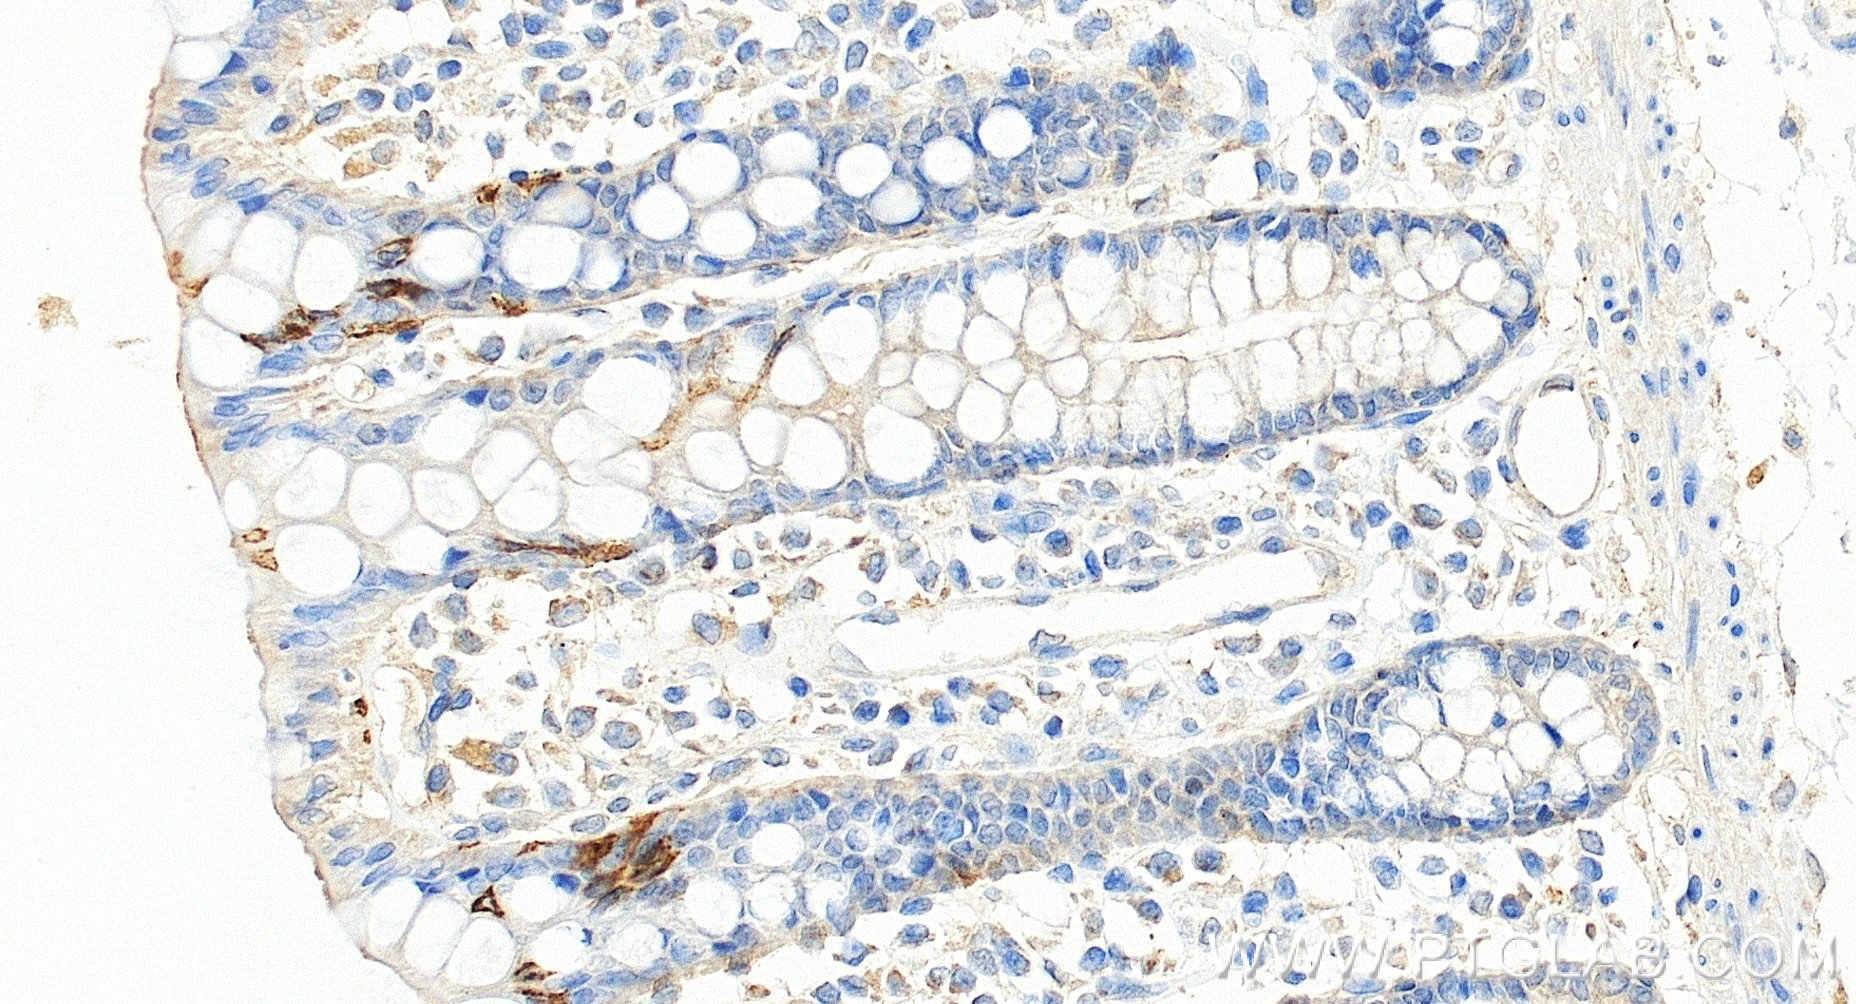
Immunohistochemistry (IHC) staining of human colon tissue using TRPA1 Recombinant monoclonal antibody (84986-3-RR)

Product Information
84986-3-PBS targets TRPA1 in WB, IHC, Indirect ELISA applications and shows reactivity with human, mouse, rat samples.
| Tested Reactivity | human, mouse, rat |
| Host / Isotype | Rabbit / IgG |
| Class | Recombinant |
| Type | Antibody |
| Immunogen |
Peptide Predict reactive species |
| Full Name | transient receptor potential cation channel, subfamily A, member 1 |
| Calculated Molecular Weight | 140 kDa |
| Observed Molecular Weight | 130 kDa |
| GenBank Accession Number | NM_007332 |
| Gene Symbol | TRPA1 |
| Gene ID (NCBI) | 8989 |
| Conjugate | Unconjugated |
| Form | Liquid |
| Purification Method | Protein A purification |
| UNIPROT ID | O75762 |
| Storage Buffer | PBS only, pH 7.3. |
| Storage Conditions | Store at -80°C. |
Background Information
TRPA1, also named as ANKTM1, belongs to the transient receptor family. TRPA1 is a receptor-activated non-selective cation channel involved in detection of pain and possibly also in cold perception and inner ear function. TRPA1 has a central role in the pain response to endogenous inflammatory mediators and to a diverse array of volatile irritants, such as mustard oil, garlic and acrolein, an irritant from tears gas and vehicule exhaust fumes. It acts also as a ionotropic cannabinoid receptor by being activated by delta(9)-tetrahydrocannabinol (THC), the psychoactive component of marijuana. It may be a component for the mechanosensitive transduction channel of hair cells in inner ear, thereby participating in the perception of sounds.